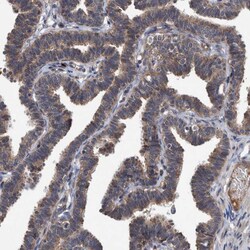

Promotional price valid on web orders only. Your contract pricing may differ. Interested in signing up for a dedicated account number?
Learn More
Learn More
Invitrogen™ ITIH3 Polyclonal Antibody


Rabbit Polyclonal Antibody
Supplier: Invitrogen™ PA553597
Description
Immunogen sequence: NDLTFTEEVD MKEMEKALQE RDYIFGNYIE RLWAYLTIEQ LLEKRKNAHG EEKENLTARA LDLSLKYHFV TPLTSMVVTK PEDNEDERAI ADKPGEDAEA TPVSPAMSYL TSYQPPQ Highest antigen sequence identity to the following orthologs: Mouse - 77%, Rat - 77%.
This gene encodes the heavy chain subunit of the pre-alpha-trypsin inhibitor complex. This complex may stabilize the extracellular matrix through its ability to bind hyaluronic acid. Polymorphisms of this gene may be associated with increased risk for schizophrenia and major depressive disorder. This gene is present in an inter-alpha-trypsin inhibitor family gene cluster on chromosome 3.
Specifications
| ITIH3 | |
| Polyclonal | |
| Unconjugated | |
| ITIH3 | |
| AW108094; H3P; inter-alpha (globulin) inhibitor H3; inter-alpha (globulin) inhibitor, H3 polypeptide; inter-alpha trypsin inhibitor, heavy chain 3; inter-alpha-inhibitor H3 chain; inter-alpha-inhibitor heavy chain 3; inter-alpha-trypsin inhibitor heavy chain 3; inter-alpha-trypsin inhibitor heavy chain H3; Intin3; ITI heavy chain H3; ITIH3; Itih-3; ITI-HC3; PAIHC3; pre-alpha (globulin) inhibitor, H3 polypeptide; pre-alpha-inhibitor heavy chain 3; pre-alpha-inhibitor, heavy chain 3; serum-derived hyaluronan-associated protein; SHAP | |
| Rabbit | |
| Antigen Affinity Chromatography | |
| RUO | |
| 3699 | |
| Store at 4°C short term. For long term storage, store at -20°C, avoiding freeze/thaw cycles. | |
| Liquid |
| Immunohistochemistry (Paraffin) | |
| 0.4 mg/mL | |
| PBS with 40% glycerol and 0.02% sodium azide; pH 7.2 | |
| Q06033 | |
| ITIH3 | |
| Recombinant protein corresponding to Human ITIH3. Recombinant protein control fragment (Product #RP-93704). | |
| 100 μL | |
| Primary | |
| Human | |
| Antibody | |
| IgG |
Product Content Correction
Your input is important to us. Please complete this form to provide feedback related to the content on this product.
Product Title
Spot an opportunity for improvement?Share a Content Correction